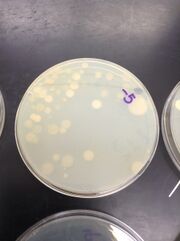
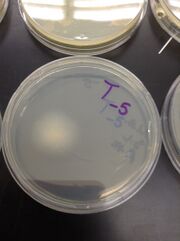

Uploads by Makuo C. Aneke
From OpenWetWare
Jump to navigationJump to search
This special page shows all uploaded files.
| Date | Name | Thumbnail | Size | Description |
|---|---|---|---|---|
| 20:20, 25 April 2014 | Serial Dilution Results 001.jpg (file) |  |
2.24 MB | |
| 20:20, 25 April 2014 | Embryo comparison.JPG (file) |  |
1.46 MB | |
| 20:17, 25 April 2014 | Description of Plants 001.jpg (file) |  |
2 MB | |
| 20:16, 25 April 2014 | Fungi 001.jpg (file) |  |
67 KB | |
| 20:16, 25 April 2014 | 10-9.jpg (file) |  |
1.05 MB | |
| 20:16, 25 April 2014 | 10-7.jpg (file) |  |
1.01 MB | |
| 20:12, 25 April 2014 | 10-7 (tet).jpg (file) |  |
1.24 MB | |
| 20:12, 25 April 2014 | 10-5.jpg (file) | |
1.28 MB | |
| 20:12, 25 April 2014 | 10-5 (tet).jpg (file) | |
1.11 MB | |
| 20:12, 25 April 2014 | 10-3 (tet).jpg (file) |  |
1.13 MB | |
| 20:12, 25 April 2014 | 10-3.jpg (file) |  |
1.23 MB | |
| 20:11, 25 April 2014 | Bacteria Results 001.jpg (file) |  |
1.99 MB | |
| 20:08, 25 April 2014 | H.I. Organisms.jpg (file) |  |
1.7 MB | |
| 20:05, 25 April 2014 | Serial Dilution 001.jpg (file) |  |
1.85 MB |